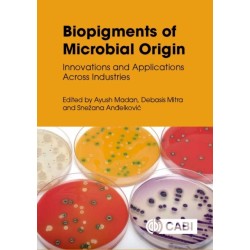
Biopigments of Microbial Origin: Innovations and Applications Across Industries

Ingen varer
CABI Publishing Forlag
Visning: Type : Alle | Sprog : Alle | Format : Hardback
-
Bemærk: Kan ikke garanteres før jul.
Environmental Horticulture: Science and Management of Green Landscapes (Bog, Hardback, Engelsk)Environmental horticulture is horticulture we encounter in our daily lives. It includes parks, botanic gardens, sports facilities,... Læs mere
Status: Kan forudbestilles -
Bemærk: Kan ikke leveres før jul.
Emotional Wellbeing in the Domestic Dog (Bog, Hardback, Engelsk)This book considers how to improve the emotional wellbeing of pet dogs, covering key topics such as optimising health, minimising pain, daily routines, handling,... Læs mere
Levering: Skaffevare (forvent 14 - 30 hverdage) -
Bemærk: Kan ikke garanteres før jul.
Managing Artists in the Music Industries: An Examination of the Key Role in Music Creator Development (Bog, Hardback, Engelsk)Music artist managers are a pivotal yet understudied part of the music industry. The development of... Læs mere
Status: Kan forudbestilles -
Bemærk: Kan leveres før jul.
Letters on Animal Welfare from the Road to Eden (Bog, Hardback, Engelsk)Combining and reflecting on the earlier works of John Webster, this book reinspects the extended journey of animal welfare science from Animal Machines through sentience, autonomy, the Five Freedoms, welfare quality assurance schemes and sustainability.
Levering: 6 - 9 hverdage -
Bemærk: Kan ikke garanteres før jul.
Fermented Foods and Beverages: Functionalities and Nutritional Aspects (Bog, Hardback, Engelsk)This book discusses the origin and evolution of fermented foods, giving an overview of the microorganisms involved in food... Læs mere
Status: Kan forudbestilles -
Bemærk: Kan ikke garanteres før jul.
Aquaponics: Combining Aquaculture and Hydroponics (Bog, Hardback, Engelsk)Covers the theory, concepts and approaches of aquaponics - a technology that integrates aquaculture and hydroponics - and its potential as a sustainable food production system.
Status: Kan forudbestilles -
Bemærk: Kan ikke garanteres før jul. Se dato på varen.
Deep Learning in Plant Science and Agricultural Biotechnology (Bog, Hardback, Engelsk)This wide-ranging book introduces the fundamentals of deep learning models and their current applications across a diversity of topics in agricultural biotechnology, crop science and plant biology.
Levering: Skaffevare (forvent 14 - 30 hverdage) (Forventes d. 15-12-2025) -
Bemærk: Kan ikke garanteres før jul. Se dato på varen.
Agrifood Waste as Biofertilizer (Bog, Hardback, Engelsk)This book demonstrates how biofertilizers from agrifood waste are an ideal candidate to replace chemical fertilizers and promote more sustainable agriculture. It provides... Læs mere
Levering: Kan forudbestilles (Forventes d. 16-12-2025) -
Bemærk: Kan ikke leveres før jul.
Other Effective Area-based Conservation Measures (OECM) in Marine Capture Fisheries: Identification, Use and Performance Assessment (Bog, Hardback, Engelsk)This book describes the OECM concept in the context of marine capture fisheries. It also helps the conservation community understand the implications of the CBD decision for the fishery sector and promotes the convergence of conservation and economic governance.
Levering: Skaffevare (forvent 14 - 30 hverdage) -
Bemærk: Kan ikke garanteres før jul. Se dato på varen.
Farm Management in a Changing World: Improving Smallholder Livelihoods in Low-income Countries (Bog, Hardback, Engelsk)This book looks at farm management from the viewpoint of smallholder farmers in developing countries. It... Læs mere
Levering: Kan forudbestilles (Forventes d. 15-12-2025) -
Bemærk: Kan ikke garanteres før jul. Se dato på varen.
Biopigments of Microbial Origin: Innovations and Applications Across Industries (Bog, Hardback, Engelsk)This book explores pigments produced by microorganisms such as bacteria, fungi, and algae. These pigments have gained significant attention due to their ecofriendly nature and diverse applications across a huge range of industries.
Levering: Kan forudbestilles (Forventes d. 15-12-2025) -
Bemærk: Kan ikke leveres før jul.
Sustainable Food Systems in the Global South: Performance Trends, Vulnerabilities and Policy Frameworks (Bog, Hardback, Engelsk)This book draws on empirical studies to gain practical insights into the issues concerning... Læs mere
Levering: Skaffevare (forvent 14 - 30 hverdage)